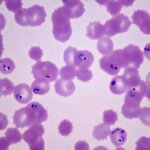

Na casa da aposentada Miriam Ferraz, 67 anos, não há espaço para descuidos. Plantas sem pratinhos que acumulam água e as demais áreas da residência devidamente limpas são motivos de elogios dos Agentes de Vigilância Ambiental (AVAs). “Sempre recebo os agentes com alegria. Eles me orientam e, graças a Deus, minha casa está sempre protegida. Já tive dengue antes, quase morri, e não quero passar por isso de novo”, contou Miriam, que também adota o uso de repelentes para garantir a saúde da família.

“Sempre recebo os agentes com alegria. Eles me orientam e, graças a Deus, minha casa está sempre protegida”, contou a aposentada Miriam Ferraz | Fotos: Ualisson Noronha/Agência Saúde-DF
A casa de Miriam não é a única a ser visitada. Graças ao trabalho dos AVAs da Secretaria de Saúde (SES-DF), os moradores do Morro Azul, em São Sebastião, têm reforçado as medidas de prevenção contra o Aedes aegypti. As inspeções minuciosas, somadas às orientações frequentes, ajudam a comunidade a evitar criadouros do mosquito transmissor de doenças como dengue, zika e chikungunya.
“Nosso trabalho vai além de eliminar focos. Ele também é educativo. Mostramos aos moradores que ações simples, como tampar caixas d’água, limpar calhas e evitar o acúmulo de água em objetos, fazem toda a diferença. O período de chuva exige ainda mais atenção”, afirmou a agente Gracineide da Costa.

A agente Gracineide da Costa explicou que o trabalho dos AVAs vai além de eliminar focos: “Mostramos aos moradores que ações simples, como tampar caixas d’água, limpar calhas e evitar o acúmulo de água em objetos, fazem toda a diferença”
Durante a visita, os agentes de vigilância identificaram uma caixa com latas acumuladas no quintal da autônoma Maria do Livramento, 43 anos. “Essa vistoria é muito importante, pois os agentes detectam focos que, às vezes, passam despercebidos por nós, moradores”, comentou.
Além das residências, as escolas da região também são alvos das inspeções. Na visita à Escola Classe 303 de São Sebastião, os agentes trataram calhas e canaletas com água parada. “Nossa prioridade é proteger as crianças e os professores. Fazemos visitas frequentes, orientamos a equipe escolar e cuidamos de qualquer foco encontrado”, explicou a agente Josefa Ribeiro.

Os AVAs também fazem visitas frequentes às escolas de São Sebastião: “Nossa prioridade é proteger as crianças e os professores”, ressaltou a agente Josefa Ribeiro
Armas contra o mosquito
O trabalho de combate ao Aedes aegypti feito pela SES-DF tem sido reforçado com diferentes técnicas, como a aplicação de larvicidas, o uso de armadilhas para monitorar o mosquito e ferramentas tecnológicas, como mapas de calor, para direcionar as ações mais rapidamente.
Para o subsecretário de Vigilância à Saúde, Fabiano dos Anjos, essas ações são essenciais para evitar a proliferação do mosquito. “O acúmulo de água em recipientes e áreas abertas aumenta exponencialmente os criadouros, e é por isso que precisamos intensificar nossas ações. Reforçar as medidas preventivas e educativas neste momento é essencial para evitar uma epidemia, proteger a saúde da população e reduzir a sobrecarga no sistema de saúde do DF”.
*Com informações da Secretaria de Saúde (SES-DF)